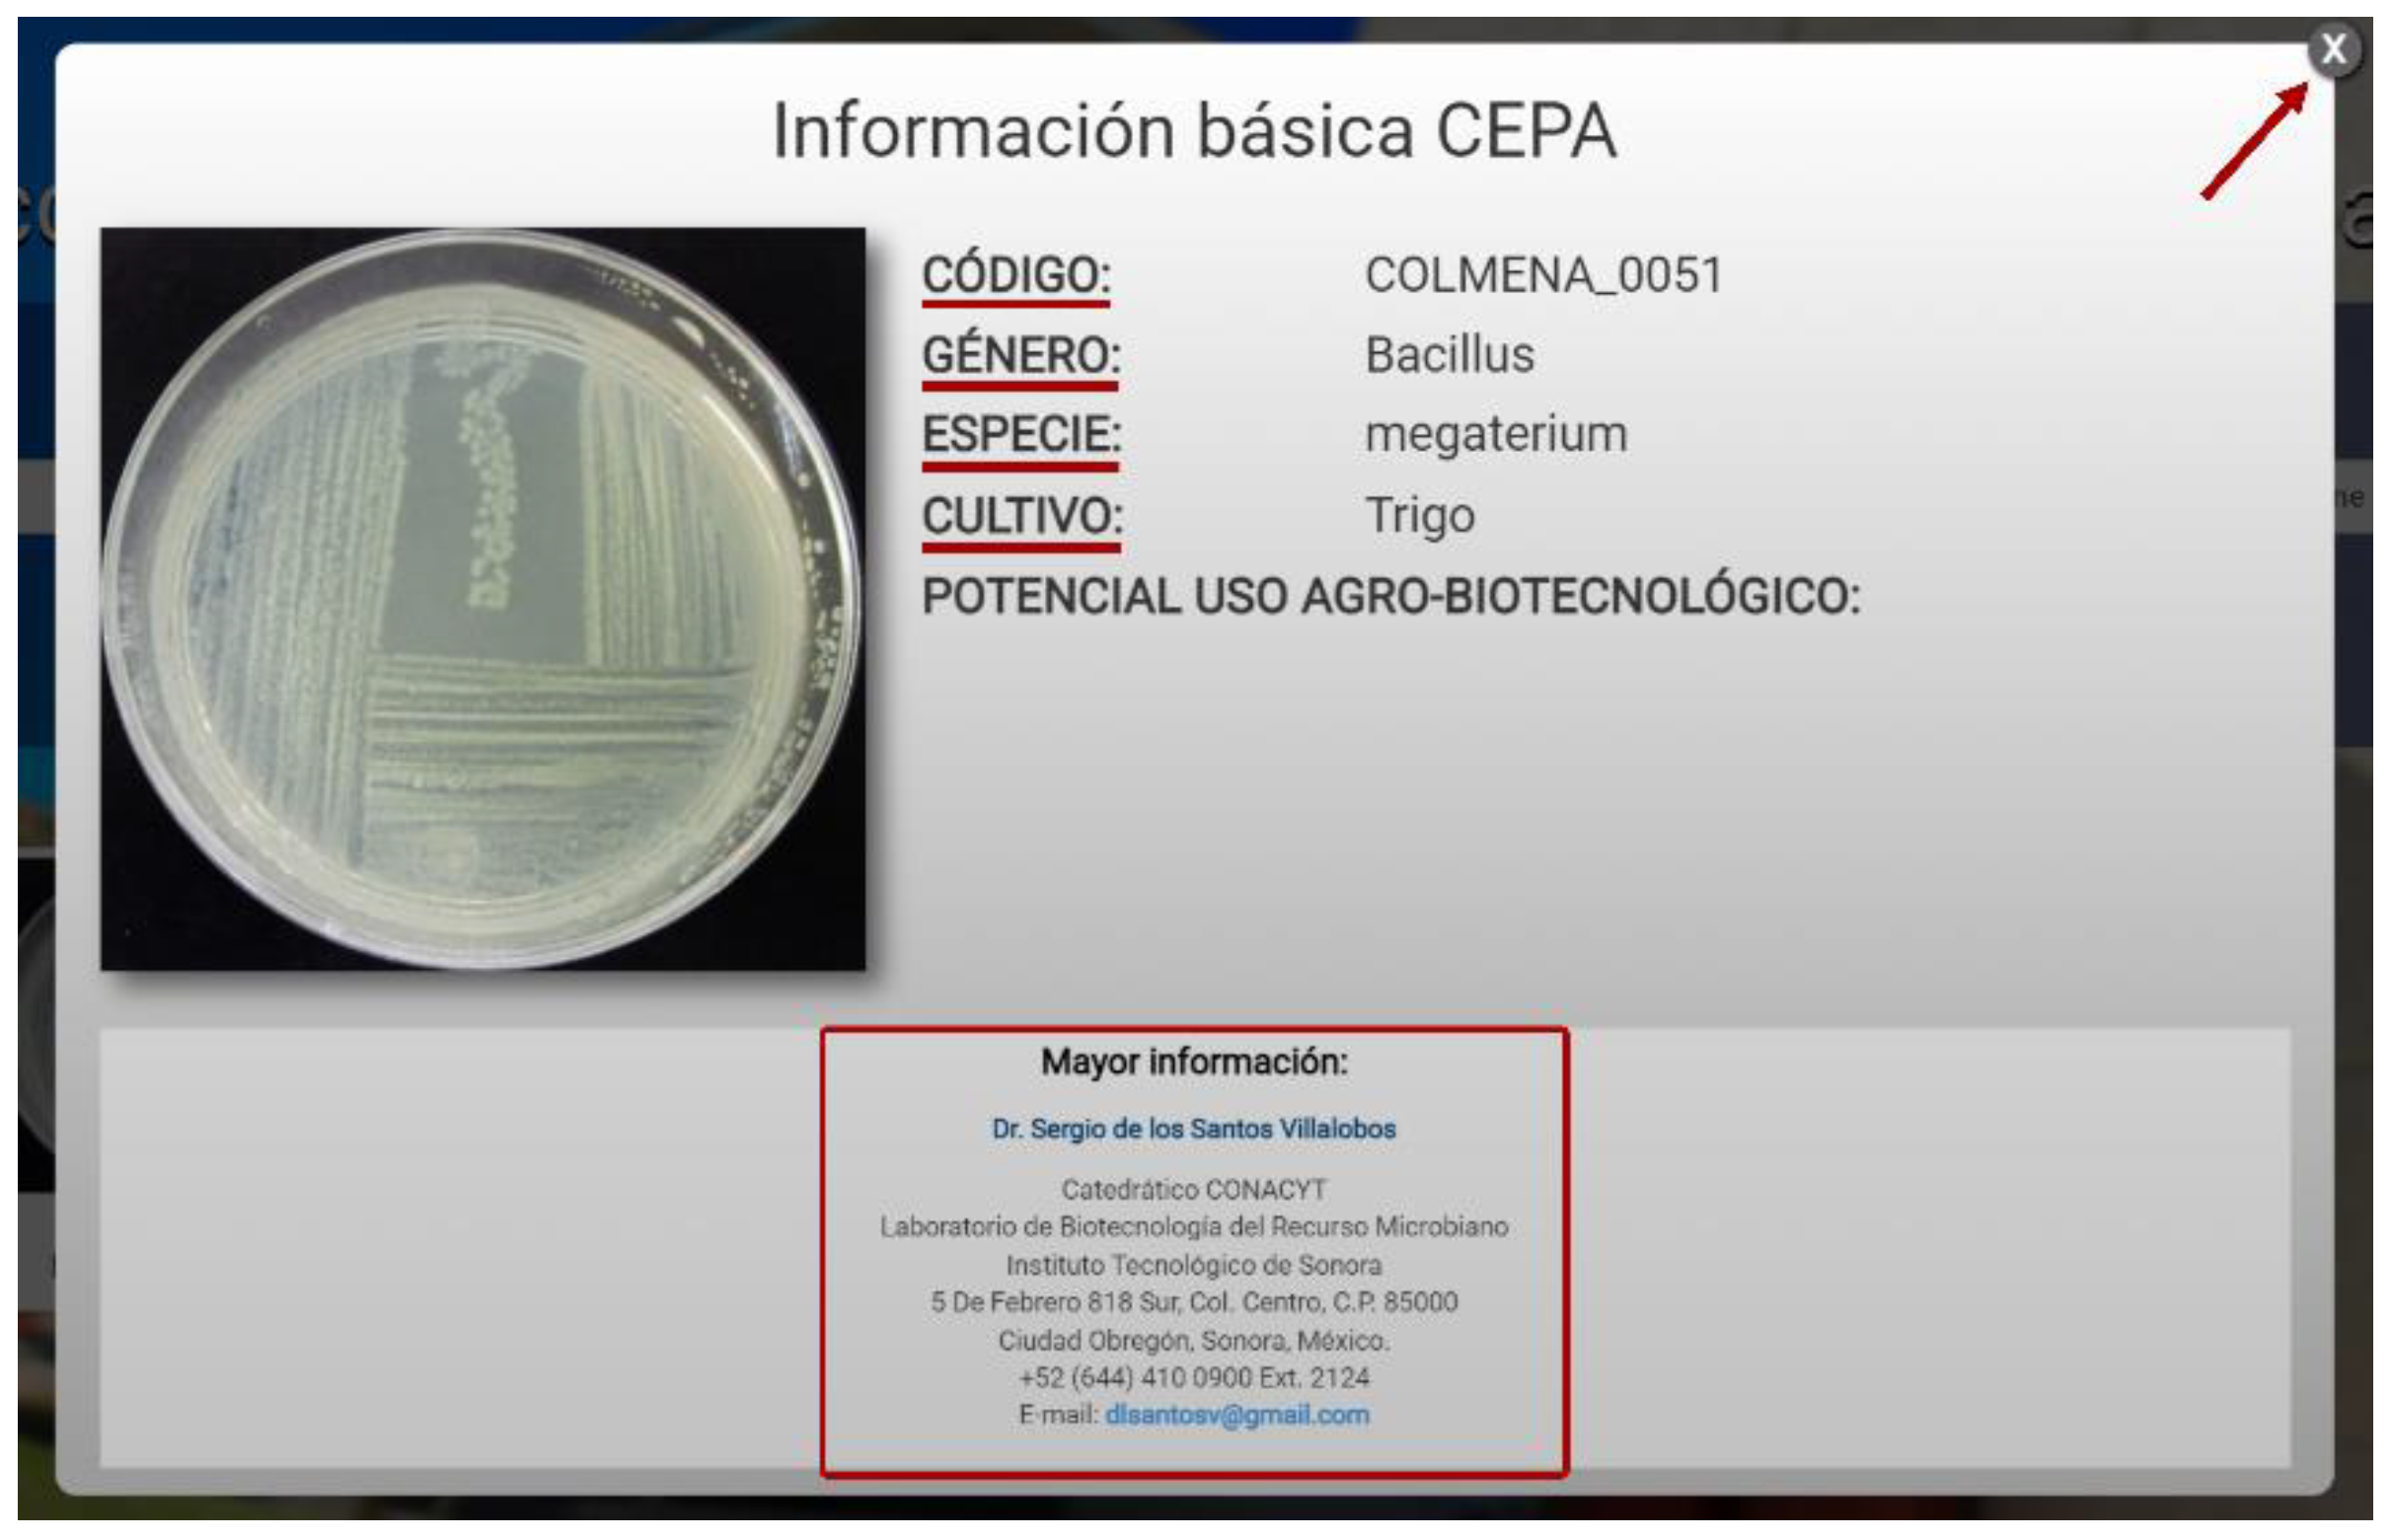

COLMENA: A Culture Collection of Native Microorganisms for Harnessing the Agro-Biotechnological Potential in Soils and Contributing to Food Security
Abstract
:1. Introduction
2. Culture Collection of Native Soil and Endophytic Microorganisms (COLMENA)
3. COLMENA and the Search for Agro-Biotechnological Alternatives
4. Virtual COLMENA Platform
5. Conclusions
Author Contributions
Funding
Institutional Review Board Statement
Informed Consent Statement
Data Availability Statement
Acknowledgments
Conflicts of Interest
References
- Díaz-Rodríguez, A.M.; Salcedo Gastelum, L.A.; Félix Pablos, C.M.; Parra-Cota, F.I.; Santoyo, G.; Puente, M.L.; Bhattacharya, D.; Mukherjee, J.; de los Santos-Villalobos, S. The Current and Future Role of Microbial Culture Collections in Food Security Worldwide. Front. Sustain. Food Syst. 2021, 4. [Google Scholar] [CrossRef]
- IPCC. Summary for Policymakers. In Global Warming of 1.5 °C an IPCC Special Report on the Impacts of Global Warming of 1.5 °C above Pre-Industrial Levels and Related Global Greenhouse Gas Emission Pathways, in the Context of Strengthening the Global Response to the Threat of Climate Change, Sustainable Development, and Efforts to Eradicate Poverty; Masson-Delmotte, V., Zhai, P., Pörtner, H.-O., Roberts, D., Skea, J., Shukla, P.R., Pirani, A., Moufouma-Okia, W., Péan, C., Pidcock, R., et al., Eds.; Intergovernmental Panel on Climate Change: Geneva, Switzerland, 2019; pp. 1–26. [Google Scholar]
- Collins, M.; Knutti, R.; Arblaster, J.; Dufresne, J.-L.; Fichefet, T.; Friedlingstein, P.; Gao, X.; Gutowski, W.J.; Johns, T.; Krinner, G.; et al. Long-Term Climate Change: Projections, Commitments and Irreversibility. In Climate Change 2013 the Physical Science Basis: Working Group I Contribution to the Fifth Assessment Report of the Intergovernmental Panel on Climate Change; Stocker, T.F., Qin, D., Plattner, G.-K., Tignor, M., Allen, S.K., Boschung, J., Nauels, A., Xia, Y., Bex, V., Midgley, P.M., Eds.; Cambridge University Press: Cambridge, MA, USA, 2013; pp. 1029–1136. [Google Scholar] [CrossRef]
- Mall, R.K.; Gupta, A.; Sonkar, G. Effect of Climate Change on Agricultural Crops. In Current Developments in Biotechnology and Bioengineering: Crop Modification, Nutrition, and Food Production; Dubey, S.K., Pandey, A., Sangwan, R.S., Eds.; Elsevier: Amsterdam, The Netherlands, 2017; pp. 23–46. [Google Scholar] [CrossRef]
- Challinor, A.J.; Watson, J.; Lobell, D.B.; Howden, S.M.; Smith, D.R.; Chhetri, N. A Meta-Analysis of Crop Yield under Climate Change and Adaptation. Nat. Clim. Chang. 2014, 4, 287–291. [Google Scholar] [CrossRef]
- Gupta, S.; Sharma, D.; Gupta, M. Climate Change Impact on Plant Diseases: Opinion, Trends and Mitigation Strategies. In Microbes for Climate Resilient Agriculture; Kashyap, P.L., Ed.; John Wiley & Sons, Inc.: Hoboken, NJ, USA, 2018; pp. 41–56. [Google Scholar] [CrossRef]
- Velásquez, A.C.; Castroverde, C.D.M.; He, S.Y. Plant and Pathogen Warfare under Changing Climate Conditions. Curr. Biol. 2018, 28, R619–R634. [Google Scholar] [CrossRef] [Green Version]
- Cerda, R.; Avelino, J.; Gary, C.; Tixier, P.; Lechevallier, E.; Allinne, C. Primary and Secondary Yield Losses Caused by Pests and Diseases: Assessment and Modeling in Coffee. PLoS ONE 2017, 12, e0169133. [Google Scholar] [CrossRef] [PubMed] [Green Version]
- FAO. The Future of Food and Agriculture—Trends and Challenges; Food and Agriculture Organization of the United Nations: Rome, Italy, 2017. [Google Scholar]
- Dudley, N.; Alexander, S. Agriculture and Biodiversity: A Review. Biodiversity 2017, 18, 45–49. [Google Scholar] [CrossRef]
- Matson, P.; Jewett, P. Ecosystems and Land-Use Change in the Yaqui Valley: Does Agricultural Intensification Spare Land for Nature? In Seeds of Sustainability: Lessons from the Birthplace of the Green Revolution; Matson, P., Ed.; Island Press: Washington, DC, USA, 2013; pp. 47–62. [Google Scholar] [CrossRef]
- Adhikari, K.; Hartemink, A.E. Linking Soils to Ecosystem Services—A Global Review. Geoderma 2016, 262, 101–111. [Google Scholar] [CrossRef]
- De los Santos-Villalobos, S.; Parra-Cota, F.I.; Herrera-Sepúlveda, A.; Valenzuela-Aragón, B.; Estrada-Mora, J.C. Colmena: Colección de Microorganismos Edáficos y Endófitos Nativos, Para Contribuir a La Seguridad Alimentaria Nacional. Rev. Mex. Cienc. Agrícolas 2018, 9, 191–202. [Google Scholar] [CrossRef] [Green Version]
- Pereira, P.; Bogunovic, I.; Muñoz-Rojas, M.; Brevik, E.C. Soil Ecosystem Services, Sustainability, Valuation and Management. Curr. Opin. Environ. Sci. Health 2018, 5, 7–13. [Google Scholar] [CrossRef]
- Valenzuela-Ruiz, V.; Ayala-Zepeda, M.; Arellano-Wattenbarger, G.L.; Parra-Cota, F.I.; García-Pereyra, G.; Aviña-Martínez, G.N.; de los Santos-Villalobos, S. Las Colecciones Microbianas y Su Potencial Contribución a La Seguridad Alimentaria Actual y Futura. Rev. Latinoam. Rec. Nat. 2018, 14, 18–25. [Google Scholar]
- Nannipieri, P.; Ascher, J.; Ceccherini, M.T.; Landi, L.; Pietramellara, G.; Renella, G. Microbial Diversity and Soil Functions. Eur. J. Soil Sci. 2003, 54, 655–670. [Google Scholar] [CrossRef]
- Sarkar, A.; Saha, M.; Meena, V.S. Plant Beneficial Rhizospheric Microbes (PBRMs): Prospects for Increasing Productivity and Sustaining the Resilience of Soil Fertility. In Agriculturally Important Microbes for Sustainable Agriculture; Meena, V.S., Mishra, P.K., Bisht, J.K., Pattanayak, A., Eds.; Springer Nature: Singapore, 2017; pp. 3–29. [Google Scholar] [CrossRef]
- ELD Initiative. Report for Policy and Decision Makers: Reaping Economic and Environmental Benefits from Sustainable Land Management; ELD Initiative: Bonn, Germany, 2015. [Google Scholar]
- Gupta, G.S. Land Degradation and Challenges of Food Security. Rev. Eur. Stud. 2019, 11, 63–72. [Google Scholar] [CrossRef]
- Tsiafouli, M.A.; Thébault, E.; Sgardelis, S.P.; de Ruiter, P.C.; van der Putten, W.H.; Birkhofer, K.; Hemerik, L.; de Vries, F.T.; Bardgett, R.D.; Brady, M.V.; et al. Intensive Agriculture Reduces Soil Biodiversity across Europe. Glob. Chang. Biol. 2015, 21, 973–985. [Google Scholar] [CrossRef]
- Zhu, Z.; Bai, Y.; Lv, M.; Tian, G.; Zhang, X.; Li, L.; Jiang, Y.; Ge, S. Soil Fertility, Microbial Biomass, and Microbial Functional Diversity Responses to Four Years Fertilization in an Apple Orchard in North China. Hortic. Plant. J. 2020, 6, 223–230. [Google Scholar] [CrossRef]
- Jacoby, R.; Peukert, M.; Succurro, A.; Koprivova, A.; Kopriva, S. The Role of Soil Microorganisms in Plant Mineral Nutrition—Current Knowledge and Future Directions. Front. Plant. Sci. 2017, 8. [Google Scholar] [CrossRef] [PubMed] [Green Version]
- Lu, H.; Wu, Z.; Wang, W.; Xu, X.; Liu, X. Rs-198 Liquid Biofertilizers Affect Microbial Community Diversity and Enzyme Activities and Promote Vitis vinifera L. Growth. Biomed. Res. Int. 2020, 2020. [Google Scholar] [CrossRef] [PubMed]
- Lisuma, J.B.; Zuberi, Z.; Ndakidemi, P.A.; Mbega, E.R. Linking Rhizosphere Bacterial Diversity and Soil Fertility in Tobacco Plants under Different Soil Types and Cropping Pattern in Tanzania: A Pilot Study. Heliyon 2020, 6. [Google Scholar] [CrossRef]
- Lei, H.; Liu, A.; Hou, Q.; Zhao, Q.; Guo, J.; Wang, Z. Diversity Patterns of Soil Microbial Communities in the Sophora Flavescens Rhizosphere in Response to Continuous Monocropping. BMC Microbiol. 2020, 20. [Google Scholar] [CrossRef] [PubMed]
- Mishra, J.; Prakash, J.; Arora, N.K. Role of Beneficial Soil Microbes in Sustainable Agriculture and Environmental Management. Clim. Chang. Environ. Sustain. 2016, 4, 137. [Google Scholar] [CrossRef]
- Trivedi, P.; Leach, J.E.; Tringe, S.G.; Sa, T.; Singh, B.K. Plant–Microbiome Interactions: From Community Assembly to Plant Health. Nat. Rev. Microbiol. 2020, 18, 607–621. [Google Scholar] [CrossRef] [PubMed]
- Gangwar, M.; Saini, P.; Nikhanj, P.; Kaur, S. Plant Growth-Promoting Microbes (PGPM) as Potential Microbial Bio-Agents for Eco-Friendly Agriculture. In Advances in Soil Microbiology: Recent Trends and Future Prospects, Microorganisms for Sustainability; Adhya, T., Mishra, B., Annapurna, K., Verma, D., Kumar, U., Eds.; Springer: Singapore, 2017; Volume 4, pp. 37–55. [Google Scholar] [CrossRef]
- Valenzuela-Ruiz, V.; Gálvez-Gamboa, G.T.; Villa-Rodríguez, E.D.; Parra-Cota, F.I.; Santoyo, G.; de los Santos-Villalobos, S. Lipopéptidos Producidos por Agentes de Control Biológico del Género Bacillus: Revisión de Herramientas Analíticas Utilizadas para su Estudio. Rev. Mex. Cienc. Agric. 2020, 11, 419–432. [Google Scholar] [CrossRef] [Green Version]
- CIMMYT. Wheat Atlas by CIMMYT. Available online: http://wheatatlas.org/visualizations (accessed on 30 July 2020).
- SAGARPA. Boletín Mensual de La Producción Trigo Grano; Secretaría de Agricultura Ganadería y Desarrollo Rural (SAGARPA): Xalapa-Enríquez, Mexico, 2015. [Google Scholar]
- SIAP. Avance de Siembras y Cosechas. Available online: http://infosiap.siap.gob.mx:8080/agricola_siap_gobmx/ResumenProducto.do (accessed on 17 May 2021).
- Parra-Cota, F.I.; de los Santos-Villalobos, S.; Lugo-Valdez, M.A.; Cruz-Ibarra, R.A.; Fuentes-Dávila, G.; Peinado-Fuentes, L.A. Potencial Agrobiotecnológico de Bacterias Aisladas de Suelos Agrícolas Asociados al Cultivo de Maíz en el Valle del Fuerte, Sinaloa. Rev. Latinoam. Rec. Nat. 2017, 13, 51–57. [Google Scholar]
- Parra-Cota, F.I.; Coronel-Acosta, C.B.; Amézquita-Avilés, C.F.; De los Santos-Villalobos, S.; Escalante-Martínez, D.I. Diversidad Metabólica de Microorganismos Edáficos Asociados al Cultivo de Maíz en el Valle del Yaqui, Sonora. Rev. Mex. Cienc. Agric. 2018, 9, 431–442. [Google Scholar] [CrossRef] [Green Version]
- Kim, Y.S.; Lee, Y.; Cheon, W.; Park, J.; Kwon, H.T.; Balaraju, K.; Kim, J.; Yoon, Y.J.; Jeon, Y. Characterization of Bacillus velezensis AK-0 as a Biocontrol Agent against Apple Bitter Rot Caused by Colletotrichum Gloeosporioides. Sci. Rep. 2021, 11. [Google Scholar] [CrossRef]
- Ansari, F.A.; Ahmad, I. Biofilm Development, Plant Growth Promoting Traits and Rhizosphere Colonization by Pseudomonas entomophila FAP1: A Promising PGPR. Adv. Microbiol. 2018, 08, 235–251. [Google Scholar] [CrossRef] [Green Version]
- Panpatte, D.G.; Jhala, Y.K.; Shelat, H.N.; Vyas, R.V. Pseudomonas fluorescens: A Promising Biocontrol Agent and PGPR for Sustainable Agriculture. In Microbial Inoculants in Sustainable Agricultural Productivity: Research Perspectives; Pratap, D., Bahadur, S., Prabha, S., Eds.; Springer: New Delhi, India, 2016; Volume 1, pp. 257–270. [Google Scholar] [CrossRef]
- Mishra, S.; Singh, B.R.; Naqvi, A.H.; Singh, H.B. Potential of Biosynthesized Silver Nanoparticles Using Stenotrophomonas Sp. BHU-S7 (MTCC 5978) for Management of Soil-Borne and Foliar Phytopathogens. Sci. Rep. 2017, 7, 45154. [Google Scholar] [CrossRef] [Green Version]
- Hung, R.; Lee Rutgers, S. Applications of Aspergillus in Plant Growth Promotion. In New and Future Developments in Microbial Biotechnology and Bioengineering; Gupta, V.K., Ed.; Elsevier: Amsterdam, The Netherlands, 2016; pp. 223–227. [Google Scholar] [CrossRef]
- Pandya, N.D.; Desai, P.V.; Jadhav, H.P.; Sayyed, R.Z. Plant Growth Promoting Potential of Aspergillus sp. NPF7, Isolated from Wheat Rhizosphere in South Gujarat, India. Environ. Sustain. 2018, 1, 245–252. [Google Scholar] [CrossRef]
- Wakelin, S.A.; Gupta, V.V.S.R.; Harvey, P.R.; Ryder, M.H. The Effect of Penicillium Fungi on Plant Growth and Phosphorus Mobilization in Neutral to Alkaline Soils from Southern Australia. Can. J. Microbiol. 2007, 53, 106–115. [Google Scholar] [CrossRef]
- Coutinho, T.C.; Ferreira, M.C.; Rosa, L.H.; de Oliveira, A.M.; de Oliveira Júnior, E.N. Penicillium citrinum and Penicillium mallochii: New Phytopathogens of Orange Fruit and Their Control Using Chitosan. Carbohydr. Polym. 2020, 234, 115918. [Google Scholar] [CrossRef]
- Elkhateeb, W.A.; Daba, G.M. Myrothecium as Promising Model for Biotechnological Applications, Potentials and Challenges. Biomed. J. Sci. Tech. Res. 2019, 16. [Google Scholar] [CrossRef]
- Díaz-Rodríguez, A.M.; Parra-Cota, F.I.; Santoyo, G.; de los Santos-Villalobos, S. Chlorothalonil Tolerance of Indole Producing Bacteria Associated to Wheat (Triticum turgidum L.) Rhizosphere in the Yaqui Valley, Mexico. Ecotoxicology 2019, 28, 569–577. [Google Scholar] [CrossRef] [PubMed]
- Escribano-Viana, R.; López-Alfaro, I.; López, R.; Santamaría, P.; Gutiérrez, A.R.; González-Arenzana, L. Impact of Chemical and Biological Fungicides Applied to Grapevine on Grape Biofilm, Must, and Wine Microbial Diversity. Front. Microbiol. 2018, 9. [Google Scholar] [CrossRef] [PubMed]
- Barea, J.M. Future Challenges and Perspectives for Applying Microbial Biotechnology in Sustainable Agriculture Based on a Better Understanding of Plant-Microbiome Interactions. J. Soil Sci. Plant. Nutr. 2015, 15, 261–282. [Google Scholar] [CrossRef]
- Hernández-Flores, L.; Munive-Hernández, A.; Sandoval-Castro, E.; Martines-Carrera, D.; Villegas-Hernández, M.C. Efecto de las Prácticas Agrícolas sobre las Poblaciones Bacterianas del Suelo en Sistemas de Cultivo en Chihuahua, México. Rev. Mex. Cienc. Agric. 2013, 4, 353–365. [Google Scholar] [CrossRef] [Green Version]
- Robles-Montoya, R.I.; Chaparro-Encinas, L.A.; Parra-Cota, F.I.; de los Santos-Villalobos, S. Improving Biometric Traits of Wheat Seedlings with the Inoculation of a Consortium Native of Bacillus. Rev. Mex. Cienc. Agric. 2020, 11, 229–235. [Google Scholar]
- Rojas-Padilla, J.; Chaparro-Encinas, L.A.; Robles-Montoya, R.I.; de los Santos-Villalobos, S. Promoción de Crecimiento En Trigo (Triticum turgidum L. subsp. durum) por la Co-Inoculación de Cepas Nativas de Bacillus Aisladas del Valle del Yaqui, México. Nov. Sci. 2020, 12, 1–27. [Google Scholar] [CrossRef]
- Valenzuela-Aragon, B.; Parra-Cota, F.I.; Santoyo, G.; Arellano-Wattenbarger, G.L.; de los Santos-Villalobos, S. Plant-Assisted Selection: A Promising Alternative for in Vivo Identification of Wheat (Triticum turgidum L. subsp. durum) Growth Promoting Bacteria. Plant. Soil 2019, 435, 367–384. [Google Scholar] [CrossRef]
- Villa-Rodríguez, E.; Parra-Cota, F.; Castro-Longoria, E.; López-Cervantes, J.; de los Santos-Villalobos, S. Bacillus subtilis TE3: A Promising Biological Control Agent against Bipolaris Sorokiniana, the Causal Agent of Spot Blotch in Wheat (Triticum turgidum L. Subsp. durum). Biol. Control. 2019, 132, 135–143. [Google Scholar] [CrossRef]
- Ibarra-Villarreal, A.L.; Gándara-Ledezma, A.; Godoy-Flores, A.; Díaz-Rodríguez, A.M.; Parra-Cota, F.I.; de los Santos-Villalobos, S. Salt-Tolerant Bacillus Species as a Promising Strategy to Mitigate the Salinity Stress in Wheat (Triticum turgidum Subsp. durum). J. Arid Environ. 2021, 186, 104399. [Google Scholar] [CrossRef]
- Parra-Cota, F.I.; García-Pereyra, J.; Aviña-Martínez, G.N.; de los Santos-Villalobos, S. Primer Reporte de Marchitamiento Por Fusarium en Citrus sinensis Var. Valencia en el Valle del Yaqui, México. Rev. Mex. Fitopatol. Mex. J. Phytopathol. 2018, 37, 193–201. [Google Scholar] [CrossRef]
- Villa-Rodriguez, E.; Lugo-Enríquez, C.; de los Santos-Villalobos, S.; Parra-Cota, F.I.; Figueroa-López, P. First Report of Cochliobolus sativus Causing Spot Blotch on Durum Wheat (Triticum durum) in The Yaqui Valley, Mexico. Plant. Dis. 2016, 100, 2329. [Google Scholar] [CrossRef]
- Sabaté, D.C.; Brandan, C.P.; Petroselli, G.; Erra-Balsells, R.; Audisio, M.C. Biocontrol of Sclerotinia sclerotiorum (Lib.) de Bary on Common Bean by Native Lipopeptide-Producer Bacillus Strains. Microbiol. Res. 2018, 211, 21–30. [Google Scholar] [CrossRef] [PubMed]
- Schloter, M.; Nannipieri, P.; Sørensen, S.J.; van Elsas, J.D. Microbial Indicators for Soil Quality. Biol. Fertil. Soils 2018, 54, 1–10. [Google Scholar] [CrossRef] [Green Version]
- Robles-Montoya, R.I.; Valenzuela-Ruiz, V.; Parra-Cota, F.I.; Santoyo, G.; de los Santos-Villalobos, S. Description of a Polyphasic Taxonomic Approach for Plant Growth-Promoting Rhizobacteria (PGPR). In Microbial Services in Restoration Ecology; Singh, J.S., Vimal, S.R., Eds.; Elsevier: Amsterdam, The Netherlands, 2020; pp. 259–269. [Google Scholar]
- Berg, G.; Zachow, C. Bacteria in Agrobiology: Crop Ecosystems. In Bacteria in Agrobiology: Crop Ecosystems; Maheshwari, D.K., Ed.; Springer: Berlin/Heidelberg, Germany, 2011; pp. 97–109. [Google Scholar] [CrossRef]
- Parnell, J.; Berka, R.; Young, H.; Sturino, J.; Kang, Y.; Barnhart, D.; Dileo, M. From the Lab to the Farm: An Industrial Perspective of Plant Beneficial Microorganisms. Front. Plant. Sci. 2016, 7, 1110. [Google Scholar] [CrossRef] [PubMed]
- Herrmann, L.; Lesueur, D. Challenges of Formulation and Quality of Biofertilizers for Successful Inoculation. Appl. Microbiol. Biotechnol. 2013, 97, 8859–8873. [Google Scholar] [CrossRef] [PubMed]
- De los Santos-Villalobos, S.; Robles-Montoya, R.I.; Parra-Cota, F.I.; Larsen, J.; Lozano, P.; Tiedje, J.M. Bacillus cabrialesii sp. nov., an Endophytic Plant Growth Promoting Bacterium Isolated from Wheat (Triticum turgidum subsp. durum) in the Yaqui Valley, Mexico. Int. J. Syst. Evol. Microbiol. 2019, 69, 3939–3945. [Google Scholar] [CrossRef]
- Robles-Montoya, R.I.; Parra-Cota, F.I.; de los Santos-Villalobos, S. Draft Genome Sequence of Bacillus megaterium TRQ8, a Plant Growth-Promoting Bacterium Isolated from Wheat (Triticum turgidum subsp. durum) Rhizosphere in the Yaqui Valley, Mexico. 3 Biotech 2019, 9, 1–5. [Google Scholar] [CrossRef]
- Valenzuela-Ruiz, V.; Robles-Montoya, R.I.; Parra-Cota, F.I.; Santoyo, G.; Orozco-Mosqueda, M.; Rodríguez-Ramírez, R.; de los Santos-Villalobos, S. Draft Genome Sequence of Bacillus paralicheniformis TRQ65, a Biological Control Agent and Plant Growth-Promoting Bacterium Isolated from Wheat (Triticum turgidum subsp. durum) Rhizosphere in the Yaqui Valley, Mexico. 3 Biotech 2019, 9, 1–7. [Google Scholar] [CrossRef]
- Villa-Rodriguez, E.; Moreno-Ulloa, A.; Castro-Longoria, E.; Parra-Cota, F.I.; de los Santos-Villalobos, S. Integrated Omics Approaches for Deciphering Antifungal Metabolites Produced by a Novel Bacillus Species, B. Cabrialesii TE3T, against the Spot Blotch Disease of Wheat (Triticum turgidum L. subsp. durum). Microbiol. Res. 2021, 251, 126826. [Google Scholar] [CrossRef]
- Ibarra-Villarreal, A.L. El Recurso Microbiano Nativo Como Alternativa Agro-Biotecnológica Para La Producción Sostenible del Trigo (Triticum turgidum L. subsp. durum) Variedad CIRNO C2008 en el Valle del Yaqui, Sonora. Ph.D. Thesis, Instituto Tecnológico de Sonora, Ciudad Obregon, Mexico, 2020. [Google Scholar]
- Arellano-Wattenbarger, G.L. Impacto de la Aplicación de un Consorcio Nativo de Bacillus sobre Características Agronómicas del Cultivo de Trigo (Triticum turgidum L. subsp. durum), Bajo Diferentes Dosis de Urea, en el Valle del Yaqui, México. Master’s Thesis, Instituto Tecnológico de Sonora, Ciudad Obregon, Mexico, 2019. [Google Scholar]
- Ayala-Zepeda, M. Impacto de la Inoculación de un Consorcio Nativo de Bacillus sobre la Eficiencia en el Uso del 15N-Fertilizante por el Trigo (Triticum turgidum L. subsp. durum) en el Valle del Yaqui, México. Master’s Thesis, Instituto Tecnológico de Sonora, Ciudad Obregón, Mexico, 2020. [Google Scholar]
- Chaparro-Encinas, L.A. Transcriptomic Study of the Plant-Plant Growth-Promoting Bacteria Interaction under Increased Temperature to Identify Genes of Agricultural Importance. Ph.D. Thesis, Instituto Tecnológico de Sonora, Ciudad Obregón, Mexico, 2020. [Google Scholar]
- Baxevanis, A.D.; Bateman, A. The Importance of Biological Databases in Biological Discovery. Curr. Protoc. Bioinforma. 2015, 50, 1.1.1–1.1.8. [Google Scholar] [CrossRef] [PubMed]
- Zhulin, I.B. Databases for Microbiologists. J. Bacteriol. 2015, 197, 2458–2467. [Google Scholar] [CrossRef] [Green Version]
- Bertsch, F.; Henríquez, C. 2015: El Año Internacional De Los Suelos. Agron. Costarric. 2015, 39, 149–155. [Google Scholar] [CrossRef]

Publisher’s Note: MDPI stays neutral with regard to jurisdictional claims in published maps and institutional affiliations. |
© 2021 by the authors. Licensee MDPI, Basel, Switzerland. This article is an open access article distributed under the terms and conditions of the Creative Commons Attribution (CC BY) license (https://creativecommons.org/licenses/by/4.0/).
Share and Cite
de los Santos-Villalobos, S.; Díaz-Rodríguez, A.M.; Ávila-Mascareño, M.F.; Martínez-Vidales, A.D.; Parra-Cota, F.I. COLMENA: A Culture Collection of Native Microorganisms for Harnessing the Agro-Biotechnological Potential in Soils and Contributing to Food Security. Diversity 2021, 13, 337. https://doi.org/10.3390/d13080337
de los Santos-Villalobos S, Díaz-Rodríguez AM, Ávila-Mascareño MF, Martínez-Vidales AD, Parra-Cota FI. COLMENA: A Culture Collection of Native Microorganisms for Harnessing the Agro-Biotechnological Potential in Soils and Contributing to Food Security. Diversity. 2021; 13(8):337. https://doi.org/10.3390/d13080337
Chicago/Turabian Stylede los Santos-Villalobos, Sergio, Alondra María Díaz-Rodríguez, María Fernanda Ávila-Mascareño, Andrea Denisse Martínez-Vidales, and Fannie Isela Parra-Cota. 2021. "COLMENA: A Culture Collection of Native Microorganisms for Harnessing the Agro-Biotechnological Potential in Soils and Contributing to Food Security" Diversity 13, no. 8: 337. https://doi.org/10.3390/d13080337
APA Stylede los Santos-Villalobos, S., Díaz-Rodríguez, A. M., Ávila-Mascareño, M. F., Martínez-Vidales, A. D., & Parra-Cota, F. I. (2021). COLMENA: A Culture Collection of Native Microorganisms for Harnessing the Agro-Biotechnological Potential in Soils and Contributing to Food Security. Diversity, 13(8), 337. https://doi.org/10.3390/d13080337

